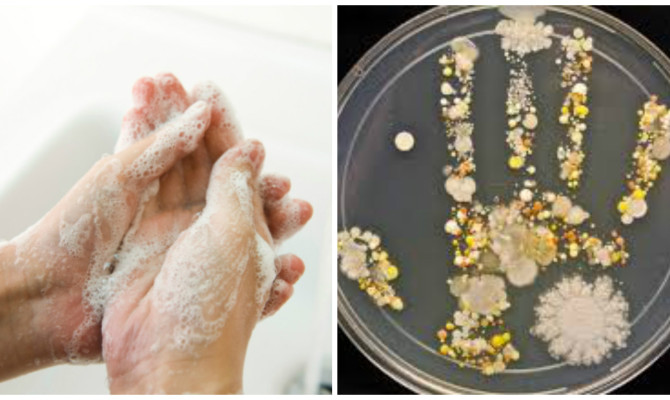
pranje ruku

Čak 95 posto ljudi to radi pogrešno, a posljedice nisu niti najmanje bezazlene. Samo pet posto ljudi pere ruke između 15 i 20 sekundi, koliko je potrebno da se ubiju bakterije i spriječi širenje bolesti, no to nije najšokantije kod ove navike koja štiti od bolesti.
Čak 95 posto ljudi to radi pogrešno, a posljedice nisu niti najmanje bezazlene. Samo pet posto ljudi pere ruke između 15 i 20 sekundi, koliko je potrebno da se ubiju bakterije i spriječi širenje bolesti, no to nije najšokantije kod ove navike koja štiti od bolesti.
Gotovo četvrtina muškaraca ne pere ruke nakon zahoda, a isto priznaje tek svaka šesta žena. No kada je u pitanju pranje ruku prije jela nastupa emancipacija – čak 61 posto odraslih ne pere ruke, pokazala je britanska studija. Iako vlažne ruke šire 1000 puta bakterija više, isti postotak priznaje i kako ne osuši ili obriše.
Američki istraživanje je pak pokazalo da umjesto 15 do 20 sekundi, koliko je preporučeno prati ruke da bi se ubile bakterije, većina je sve obavila u šest sekundi. A pokazalo se i da okolina ima utjecaj. Ako je umivaonik bio prljav, manje je ljudi opralo ruke, a ako je postojao znak koji je podsjećao ljude da operu ruke, više ih je to napravilo. A zašto je to toliko važno? Portal Modernnurse je izdvojio tri stvari koje biste morali znati o pranju ruku.
1. Čak 80 posto zaraznih bolesti prenose se dodirom
I bakterijske i virusne infekcije šire se upravo preko ruku. No rijetko je u pitanju izravan dodir – velika većina se unese u organizam tako da ih ljudi pokupe s “prometnih” mjesta – kvaka, prekidača, ručki hladnjaka….
2. Udvostručite vrijeme pranja – to ubija 10 PUTA više bakterija
Minumum minimuma pranja ruku je 15 sekundi. No ako se ruke peru 30 sekundi, na rukama ostaje 10 puta manje štetnih bakterija. To je osobito važno kada pripremate hranu, ili ste prehlađeni (ili pak brinete za nekog bolesnog).
3. Topla ili hladna voda? Nije bitno!
Hladna voda jednako učinkovito briše bakterije – razliku bi igrala eventualno kada biste pola minute prali ruke vodom od 70-80 stupnjeva . No tada biste zaradili teške opekline koje bi vam predstavljale puno veći problem od mikroba. Osim toga, topla voda više isušuje kožu, što može biti problem ako često perete ruke. Primjerice, službena preporuka za sestre je mlaka voda. piše






























